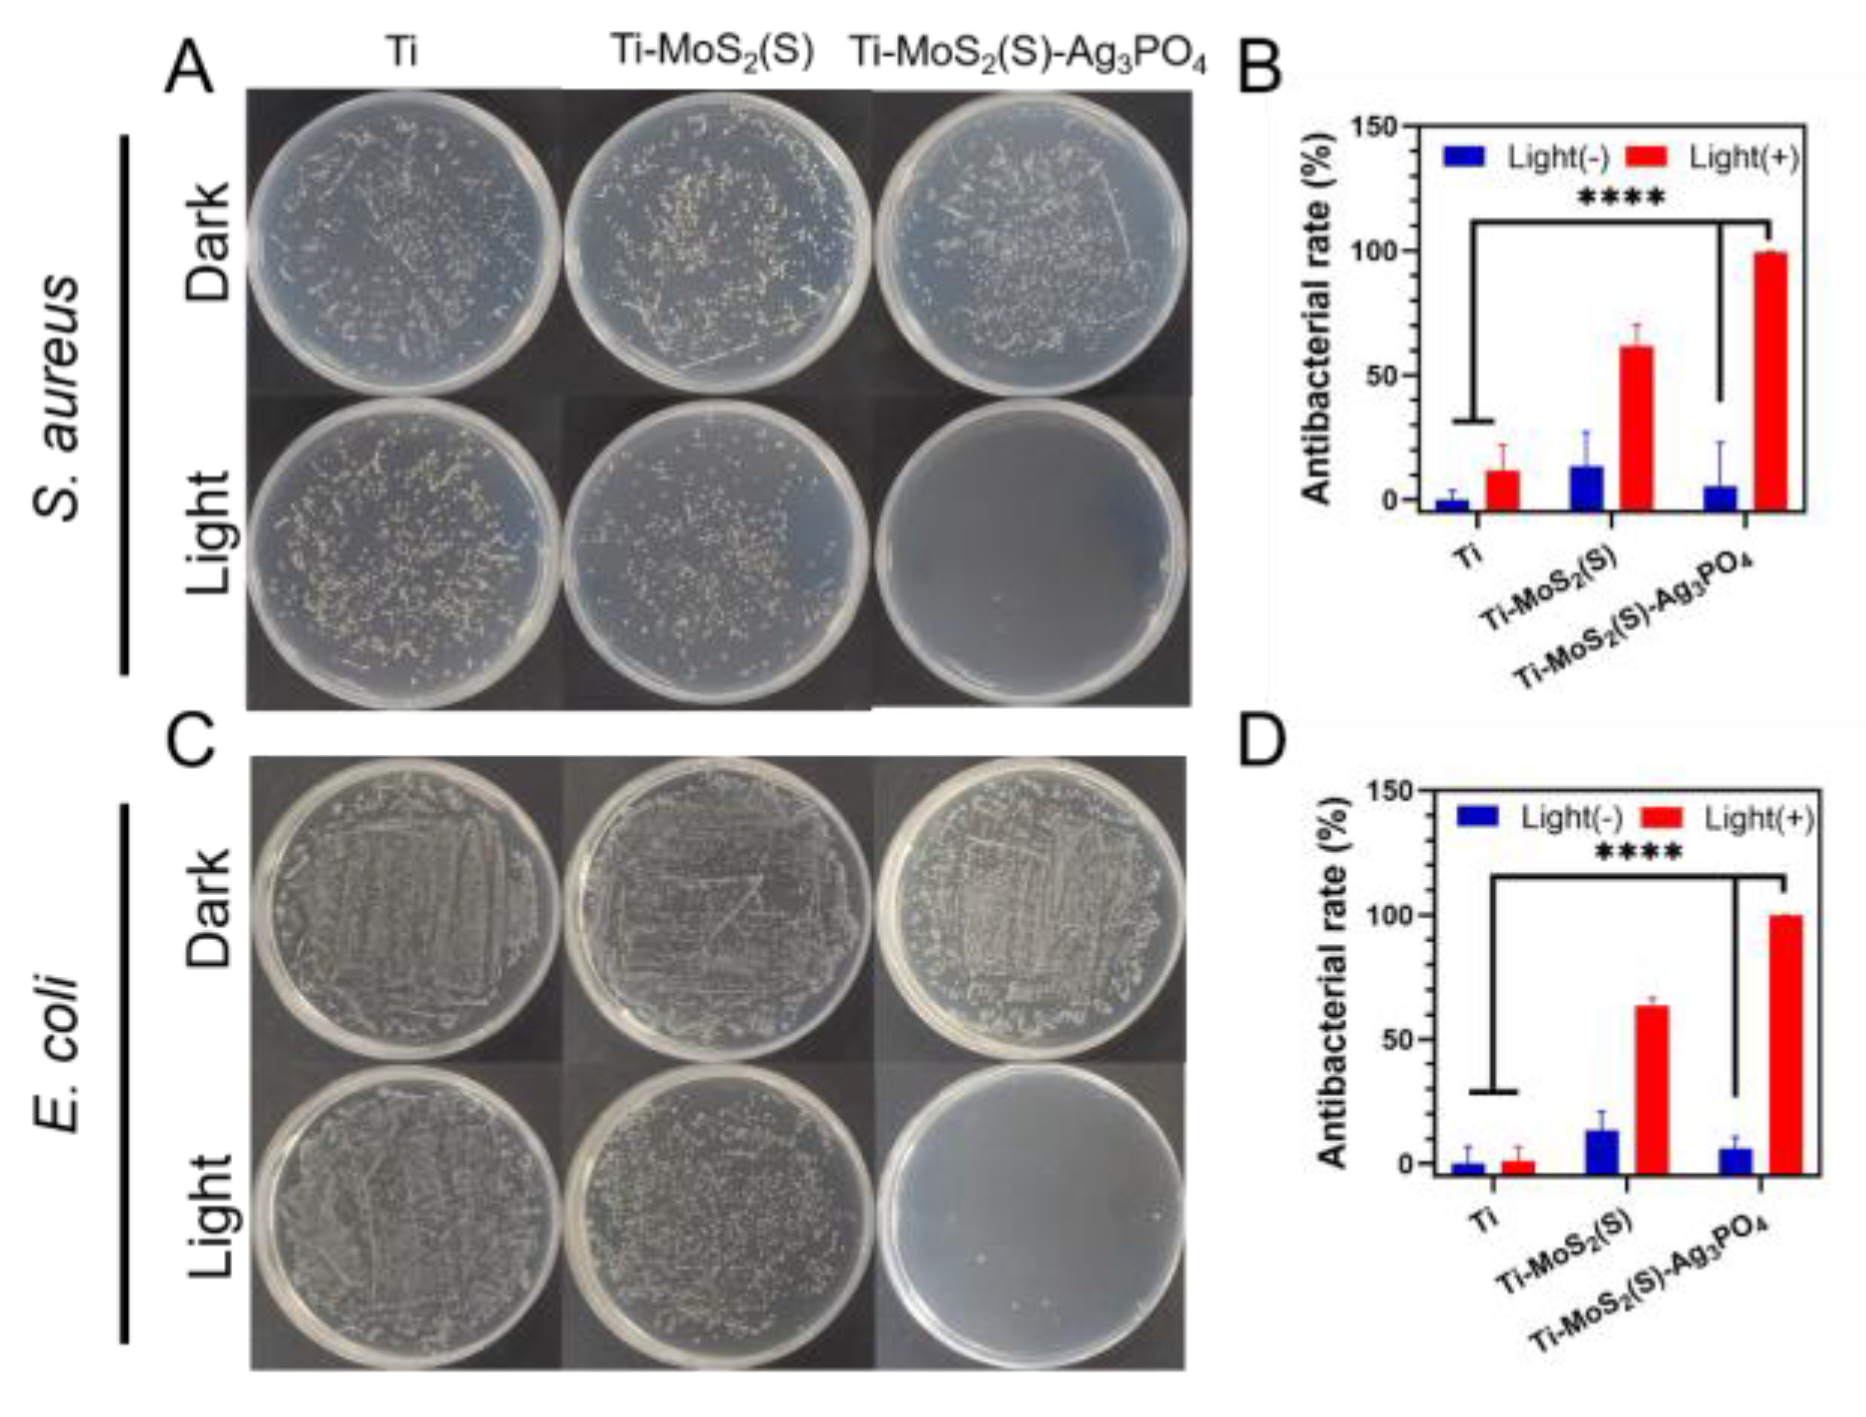
Coatings 12 01263 g007

Near-Infrared-Activated MoS2(S)–Ag3PO4 Coating for Rapid Bacteria-Killing
Abstract
:1. Introduction
2. Materials and Methods
2.1. Pretreatment of Ti Plates
2.2. MoS2 Coating Preparation
2.3. Preparation of MoS2(S)–Ag3PO4 Coating
2.4. Characterization
2.5. Photothermal Performance
2.6. Ag Ions Release
2.7. In Vitro Antimicrobial Tests
2.8. Biocompatibility Evaluation In Vitro
2.9. Statistical Analysis
3. Results
3.1. Morphologies and Structure
3.2. Photocatalytic Property
3.3. Photothermal Property
3.4. In Vitro Antibacterial Activity
3.5. In Vitro Cytotoxicity Test
4. Conclusions
Supplementary Materials
Author Contributions
Funding
Institutional Review Board Statement
Informed Consent Statement
Data Availability Statement
Conflicts of Interest
References
- Attar, H.; Ehtemam-Haghighi, S.; Kent, D.; Dargusch, M.S. Recent Developments and Opportunities in Additive Manufacturing of Titanium-Based Matrix Composites: A Review. Int. J. Mach. Tools Manuf. 2018, 133, 85–102. [Google Scholar] [CrossRef]
- Tan, L.; Li, J.; Liu, X.; Cui, Z.; Yang, X.; Zhu, S.; Li, Z.; Yuan, X.; Zheng, Y.; Yeung, K.W.K.; et al. Rapid Biofilm Eradication on Bone Implants Using Red Phosphorus and Near-Infrared Light. Adv. Mater. 2018, 30, e1801808. [Google Scholar] [CrossRef] [PubMed]
- Campoccia, D.; Montanaro, L.; Arciola, C.R. A Review of the Biomaterials Technologies for Infection-Resistant Surfaces. Biomaterials 2013, 34, 8533–8554. [Google Scholar] [CrossRef] [PubMed]
- Qiao, Y.; Liu, X.; Li, B.; Han, Y.; Zheng, Y.; Yeung, K.W.K.; Li, C.; Cui, Z.; Liang, Y.; Li, Z.; et al. Treatment of MRSA-Infected Osteomyelitis Using Bacterial Capturing, Magnetically Targeted Composites with Microwave-Assisted Bacterial Killing. Nat. Commun. 2020, 11, 4446. [Google Scholar] [CrossRef]
- Ji, H.; Dong, K.; Yan, Z.; Ding, C.; Chen, Z.; Ren, J.; Qu, X. Bacterial Hyaluronidase Self-Triggered Prodrug Release for Chemo-Photothermal Synergistic Treatment of Bacterial Infection. Small 2016, 12, 6200–6206. [Google Scholar] [CrossRef]
- Lazar, V.; Martins, A.; Spohn, R.; Daruka, L.; Grezal, G.; Fekete, G.; Szamel, M.; Jangir, P.K.; Kintses, B.; Csorgo, B.; et al. Antibiotic-Resistant Bacteria Show Widespread Collateral Sensitivity to Antimicrobial Peptides. Nat. Microbiol. 2018, 3, 718–731. [Google Scholar] [CrossRef] [PubMed]
- Li, J.; Li, Z.; Liu, X.; Li, C.; Zheng, Y.; Yeung, K.W.K.; Cui, Z.; Liang, Y.; Zhu, S.; Hu, W.; et al. Interfacial Engineering of Bi2S3/Ti3C2TX MXene Based on Work Function for Rapid Photo-Excited Bacteria-Killing. Nat. Commun. 2021, 12, 1224. [Google Scholar] [CrossRef]
- Tan, L.; Li, J.; Liu, X.; Cui, Z.; Yang, X.; Yeung, K.W.K.; Pan, H.; Zheng, Y.; Wang, X.; Wu, S. In Situ Disinfection through Photoinspired Radical Oxygen Species Storage and Thermal-Triggered Release from Black Phosphorous with Strengthened Chemical Stability. Small 2018, 14, 1703197. [Google Scholar] [CrossRef]
- Jampilek, J.; Kralova, K. Advances in Nanostructures for Antimicrobial Therapy. Materials 2022, 15, 2388. [Google Scholar] [CrossRef]
- Li, M.; Li, L.; Su, K.; Liu, X.; Zhang, T.; Liang, Y.; Jing, D.; Yang, X.; Zheng, D.; Cui, Z.; et al. Highly Effective and Noninvasive Near-Infrared Eradication of a Staphylococcus aureus Biofilm on Implants by a Photoresponsive Coating within 20 Min. Adv. Sci. 2019, 6, 1900599. [Google Scholar] [CrossRef] [Green Version]
- Li, Y.; Liu, X.; Tan, L.; Cui, Z.; Jing, D.; Yang, X.; Liang, Y.; Li, Z.; Zhu, S.; Zheng, Y.; et al. Eradicating Multidrug-Resistant Bacteria Rapidly Using a Multi-Functional g-C3N4@ Bi2S3 Nanorod Heterojunction with or without Antibiotics. Adv. Funct. Mater. 2019, 29, 1900946. [Google Scholar] [CrossRef]
- Lishchynskyi, O.; Shymborska, Y.; Stetsyshyn, Y.; Raczkowska, J.; Skirtach, A.G.; Peretiatko, T.; Budkowski, A. Passive Antifouling and Active Self-disinfecting Antiviral Surfaces. Chem. Eng. J. 2022, 446, 137048. [Google Scholar] [CrossRef] [PubMed]
- Kumar, P.; Roy, S.; Sarkar, A.; Jaiswal, A. Reusable MoS2-modified Antibacterial Fabrics with Photothermal Disinfection Properties for Repurposing of Personal Protective Masks. ACS Appl. Mater. Interfaces 2021, 13, 12912–12927. [Google Scholar] [CrossRef] [PubMed]
- Liu, X.; Hersam, M.C. Interface Characterization and Control of 2D Materials and Heterostructures. Adv. Mater. 2018, 30, e1801586. [Google Scholar] [CrossRef] [PubMed]
- Gopalakrishnan, D.; Damien, D.; Shaijumon, M.M. MoS2 Quantum Dot-Interspersed Exfoliated MoS2 Nanosheets. ACS Nano 2014, 8, 5297–5303. [Google Scholar] [CrossRef]
- Yi, Z.; Ye, J.; Kikugawa, N.; Kako, T.; Ouyang, S.; Stuart-Williams, H.; Yang, H.; Cao, J.; Luo, W.; Li, Z.; et al. An Orthophosphate Semiconductor with Photooxidation Properties under Visible-Light Irradiation. Nat. Mater. 2010, 9, 559–564. [Google Scholar] [CrossRef]
- Hong, L.; Liu, X.; Tan, L.; Cui, Z.; Yang, X.; Liang, Y.; Li, Z.; Zhu, S.; Zheng, Y.; Yeung, K.W.K.; et al. Rapid Biofilm Elimination on Bone Implants Using Near-Infrared-Activated Inorganic Semiconductor Heterostructures. Adv. Healthc. Mater. 2019, 8, 1900835. [Google Scholar] [CrossRef]
- Fu, J.; Zhu, W.; Liu, X.; Liang, C.; Zheng, Y.; Li, Z.; Liang, Y.; Zheng, D.; Zhu, S.; Cui, Z.; et al. Self-Activating Anti-Infection Implant. Nat. Commun. 2021, 12, 6907. [Google Scholar] [CrossRef]
- Zhu, M.; Liu, X.; Tan, L.; Cui, Z.; Liang, Y.; Li, Z.; Yeung, K.W.K.; Wu, S. Photo-Responsive Chitosan/Ag/MoS2 for Rapid Bacteria-Killing. J. Hazard. Mater. 2020, 383, 121122. [Google Scholar] [CrossRef]
- Sheng, B.; Liu, J.; Li, Z.; Wang, M.; Zhu, K.; Qiu, J.; Wang, J. Effects of Excess Sulfur Source on the Formation and Photocatalytic Properties of Flower-Like MoS2 Spheres by Hydrothermal Synthesis. Mater. Lett. 2015, 144, 153–156. [Google Scholar] [CrossRef]
- Liu, Y.; Fang, L.; Lu, H.; Li, Y.; Hu, C.; Yu, H. One-Pot Pyridine-Assisted Synthesis of Visible-Light-Driven Photocatalyst Ag/Ag3PO4. Appl. Catal. B Environ. 2012, 115, 245–252. [Google Scholar] [CrossRef]
- Fahmy, A.; Friedrich, J.; Poncin-Epaillard, F.; Debarnot, D. Plasma Polymerized Allyl Alcohol/O2 Thin Films Embedded with Silver Nanoparticles. Thin Solid Film. 2016, 616, 339–347. [Google Scholar] [CrossRef]
- Fahmy, A.; Jácome, L.A.; Schönhals, A. Effect of Silver Nanoparticles on the Dielectric Properties and the Homogeneity of Plasma Poly (acrylic acid) Thin Films. J. Phys. Chem. C 2020, 124, 22817–22826. [Google Scholar] [CrossRef]
- Xu, J.-W.; Gao, Z.-D.; Han, K.; Liu, Y.; Song, Y.-Y. Synthesis of Magnetically Separable Ag3PO4/TiO2/Fe3O4 Heterostructure with Enhanced Photocatalytic Performance under Visible Light for Photoinactivation of Bacteria. ACS Appl. Mater. Interfaces 2014, 6, 15122–15131. [Google Scholar] [CrossRef]
- Manikandan, A.; Ilango, P.R.; Chen, C.-W.; Wang, Y.-C.; Shih, Y.-C.; Lee, L.; Wang, Z.M.; Ko, H.; Chueh, Y.-L. A Superior Dye Adsorbent towards the Hydrogen Evolution Reaction Combining Active Sites and Phase-Engineering of (1T/2H) MoS2/A-MoO3 Hybrid Heterostructured Nanoflowers. J. Mater. Chem. A 2018, 6, 15320–15329. [Google Scholar] [CrossRef]
- Lee, D.; Jang, J.H.; Song, W.; Moon, J.; Kim, Y.; Lee, J.; Jeong, B.; Park, S. In situ Work-function Measurement during Chemical Transformation of MoS2 to MoO3 by Ambient-pressure X-ray Photoelectron Spectroscopy. 2D Mater. 2020, 7, 025014. [Google Scholar] [CrossRef]
- Xu, L.; Li, D.; Zhou, W.; Ding, Y.; Wu, Y.; Xu, J.; Duan, X. High-Efficiency Electrodeposition of Polyindole Nanocomposite Using MoS2 Nanosheets as Electrolytes and Their Capacitive Performance. Arab. J. Chem. 2020, 13, 6061–6071. [Google Scholar] [CrossRef]
- Raja, A.; Chaves, A.; Yu, J.; Arefe, G.; Hill, H.M.; Rigosi, A.F.; Berkelbach, T.C.; Nagler, P.; Schuller, C.; Korn, T.; et al. Coulomb Engineering of the Bandgap and Excitons in Two-Dimensional Materials. Nat. Commun. 2017, 8, 15251. [Google Scholar] [CrossRef]
- Etacheri, V.; Seery, M.K.; Hinder, S.J.; Pillai, S.C. Highly Visible Light Active TiO2−XNX Heterojunction Photocatalysts. Chem. Mater. 2010, 22, 3843–3853. [Google Scholar] [CrossRef]
- Li, J.; Liu, X.; Tan, L.; Liang, Y.; Cui, Z.; Yang, X.; Zhu, S.; Li, Z.; Zheng, Y.; Yeung, K.W.K.; et al. Light-Activated Rapid Disinfection by Accelerated Charge Transfer in Red Phosphorus/ZnO Heterointerface. Small Methods 2019, 3, 1900048. [Google Scholar] [CrossRef]
- Liu, C.; Kong, D.; Hsu, P.C.; Yuan, H.; Lee, H.W.; Liu, Y.; Wang, H.; Wang, S.; Yan, K.; Lin, D.; et al. Rapid Water Disinfection Using Vertically Aligned MoS2 Nanofilms and Visible Light. Nat. Nanotechnol. 2016, 11, 1098–1104. [Google Scholar] [CrossRef] [PubMed]
- Li, Y.; Zhang, W.; Niu, J.; Chen, Y. Mechanism of Photogenerated Reactive Oxygen Species and Correlation with the Antibacterial Properties of Engineered Metal-Oxide Nanoparticles. ACS Nano 2012, 6, 5164–5173. [Google Scholar] [CrossRef] [PubMed]
- Jiang, H.Y.; Zhou, P.; Wang, Y.; Duan, R.; Chen, C.; Song, W.; Zhao, J. Copper-Based Coordination Polymer Nanostructure for Visible Light Photocatalysis. Adv. Mater. 2016, 28, 9776–9781. [Google Scholar] [CrossRef] [PubMed]
- Laine, D.F.; Blumenfeld, A.; Cheng, I.F. Mechanistic Study of the ZEA Organic Pollutant Degradation System: Evidence for H2O2, HO•, and the Homogeneous Activation of O2 by FeIIEDTA. Ind. Eng. Chem. Res. 2008, 47, 6502–6508. [Google Scholar] [CrossRef]
- He, L.; Brasino, M.; Mao, C.; Cho, S.; Park, W.; Goodwin, A.P.; Cha, J.N. DNA-Assembled Core-Satellite Upconverting-Metal-Organic Framework Nanoparticle Superstructures for Efficient Photodynamic Therapy. Small 2017, 13, 1700504. [Google Scholar] [CrossRef]
- Lai, Y.; Dong, L.; Zhou, H.; Yan, B.; Chen, Y.; Cai, Y.; Liu, J. Coexposed Nanoparticulate Ag Alleviates the Acute Toxicity Induced by Ionic Ag+ In Vivo. Sci. Total Environ. 2020, 723, 138050. [Google Scholar] [CrossRef]
- Xu, Q.; Li, S.; Wan, Y.; Wang, S.; Ma, B.; She, Z.; Guo, L.; Gao, M.; Zhao, Y.; Jin, C.; et al. Impacts of Silver Nanoparticles on Performance and Microbial Community and Enzymatic Activity of a Sequencing Batch Reactor. J. Environ. Manag. 2017, 204, 667–673. [Google Scholar] [CrossRef]

Publisher’s Note: MDPI stays neutral with regard to jurisdictional claims in published maps and institutional affiliations. |
© 2022 by the authors. Licensee MDPI, Basel, Switzerland. This article is an open access article distributed under the terms and conditions of the Creative Commons Attribution (CC BY) license (https://creativecommons.org/licenses/by/4.0/).
Share and Cite
Xia, H.; Wang, D.; Tian, A.; Xu, Y.; Gong, H.; Li, Z.; Miao, J. Near-Infrared-Activated MoS2(S)–Ag3PO4 Coating for Rapid Bacteria-Killing. Coatings 2022, 12, 1263. https://doi.org/10.3390/coatings12091263
Xia H, Wang D, Tian A, Xu Y, Gong H, Li Z, Miao J. Near-Infrared-Activated MoS2(S)–Ag3PO4 Coating for Rapid Bacteria-Killing. Coatings. 2022; 12(9):1263. https://doi.org/10.3390/coatings12091263
Chicago/Turabian StyleXia, Honggang, Dongbin Wang, Aixian Tian, Yingde Xu, Hao Gong, Zhaoyang Li, and Jun Miao. 2022. "Near-Infrared-Activated MoS2(S)–Ag3PO4 Coating for Rapid Bacteria-Killing" Coatings 12, no. 9: 1263. https://doi.org/10.3390/coatings12091263
APA StyleXia, H., Wang, D., Tian, A., Xu, Y., Gong, H., Li, Z., & Miao, J. (2022). Near-Infrared-Activated MoS2(S)–Ag3PO4 Coating for Rapid Bacteria-Killing. Coatings, 12(9), 1263. https://doi.org/10.3390/coatings12091263

